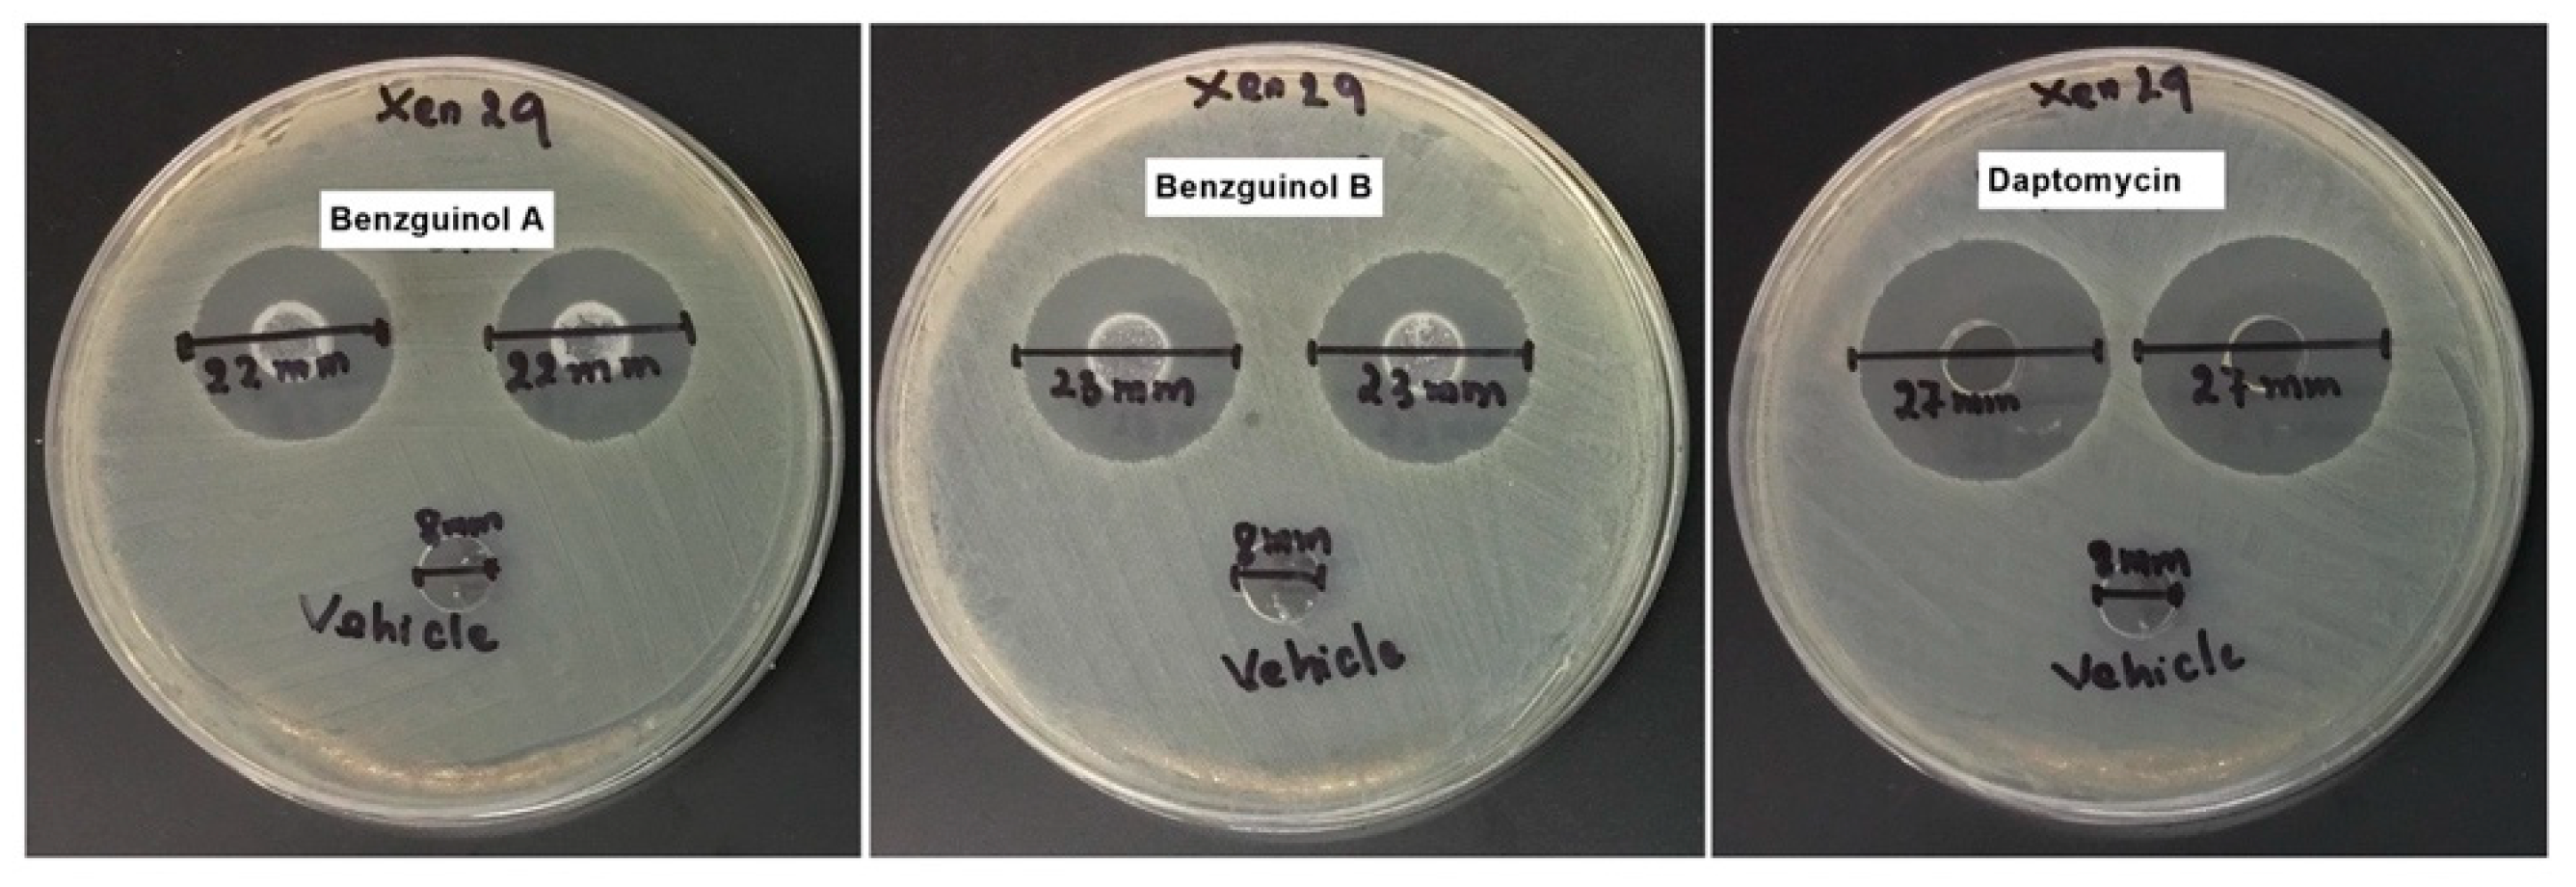
Antibiotics 10 00727 g006 Antibiotics 10 00727 g006

Evaluation of Benzguinols as Next-Generation Antibiotics for the Treatment of Multidrug-Resistant Bacterial Infections
Abstract
1. Introduction
2. Materials and Methods
2.1. Antibiotics and Chemicals Used in this Study
2.2. Organisms and Growth Conditions
2.3. Antimicrobial Susceptibility Testing
2.4. Time-Dependent Growth Inhibitory Assay
2.5. Cytotoxicity Assays
2.6. Agar Well Diffusion Method
2.7. Ethics Statements
2.8. Safety Testing of Benzguinols A and B Following Parenteral Administration
2.9. Histopathological Examination
2.10. Efficacy Testing of Benzguinols A and B after IP Challenge of Mice with Bioluminescent Gram-Positive Bacteria (GPB)
3. Results
3.1. In Vitro Activity of Benzguinols A and B Alone against GPB and in Combination with Sub-Inhibitory Concentrations of Colistin against GNB
3.2. Benzguinols A and B Exhibit Time- and Concentration-Dependent Inhibition of Bacterial Growth
3.3. Benzguinol A and Benzguinol B in Combination with Colistin Show Low Cytotoxicity to Mammalian Cell Lines
3.4. Benzguinols Show Systemic Safety in Mice
3.5. Agar Well Diffusion Test of Benzguinol Formulations Shows Antibacterial Activity
3.6. Treatment of Mice with Benzguinol A or Benzguinol B Reduces S. aureus Populations and Significantly Prolongs Survival Times
4. Discussion
5. Conclusions
Author Contributions
Funding
Institutional Review Board Statement
Informed Consent Statement
Data Availability Statement
Acknowledgments
Conflicts of Interest
References
- WHO. Antimicrobial Resistance; World Health Organization: Geneva, Switzerland, 2020. [Google Scholar]
- Chopra, I.; Schofield, C.; Everett, M.; O’Neill, A.; Miller, K.; Wilcox, M.; Frère, J.-M.; Dawson, M.; Czaplewski, L.; Urleb, U.; et al. Treatment of health-care-associated infections caused by Gram-negative bacteria: A consensus statement. Lancet Infect. Dis. 2008, 8, 133–139. [Google Scholar] [CrossRef]
- Ergönül, Ö.; Aydin, M.; Azap, A.; Başaran, S.; Tekin, S.; Kaya, Ş.; Gülsün, S.; Yörük, G.; Kurşun, E.; Yeşilkaya, A.; et al. Healthcare-associated Gram-negative bloodstream infections: Antibiotic resistance and predictors of mortality. J. Hosp. Infect. 2016, 94, 381–385. [Google Scholar] [CrossRef]
- Bassetti, M.; Peghin, M.; Vena, A.; Giacobbe, D.R. Treatment of infections due to MDR gram-negative bacteria. Front. Med. 2019, 6, 74. [Google Scholar] [CrossRef]
- CDC. Antibiotic Resistance Threats in the United States, 2019; U.S. Department of Health and Human Services, Centers for Disease Control and Prevention: Atlanta, GA, USA, 2019; pp. 1–150.
- WHO. New Report Calls for Urgent Action to Avert Antimicrobial Resistance Crisis; Joint news release; World Health Organization: Geneva, Switzerland, 2019. [Google Scholar]
- O’Neill, J.; Davies, S.; Rex, J.; White, L.; Murray, R. Review on Antimicrobial Resistance, Tackling Drug-Resistant Infections Globally: Final Report and Recommendations; Wellcome Trust and UK Government: London, UK, 2016. [Google Scholar]
- Hart, J.; Christiansen, K.J.; Lee, R.; Heath, C.H.; Coombs, G.W.; Robinson, J.O. Increased EMRSA-15 health-care worker colonization demonstrated in retrospective review of EMRSA hospital outbreaks. Antimicrob. Resist. Infect. Control 2014, 3, 7. [Google Scholar] [CrossRef] [PubMed][Green Version]
- Knox, J.; Van Rijen, M.; Uhlemann, A.-C.; Miller, M.; Hafer, C.; Vavagiakis, P.; Shi, Q.; Johnson, P.D.R.; Coombs, G.; Kluytmans-Van Den Bergh, K.-V.D.; et al. Community-associated methicillin-resistant Staphylococcus aureus transmission in households of infected cases: A pooled analysis of primary data from three studies across international settings. Epidemiol. Infect. 2015, 143, 354–365. [Google Scholar] [CrossRef] [PubMed]
- Valiquette, L.; Chakra, C.N.A.; Laupland, K.B. Financial impact of health care-associated infections: When money talks. Can. J. Infect. Dis. Med. Microbiol. 2014, 25, 71–74. [Google Scholar] [CrossRef] [PubMed]
- McCarthy, A.J.; Harrison, E.M.; Stanczak-Mrozek, K.; Leggett, B.; Waller, A.; Holmes, M.A.; Lloyd, D.H.; Lindsay, J.A.; Loeffler, A. Genomic insights into the rapid emergence and evolution of MDR in Staphylococcus pseudintermedius. J. Antimicrob. Chemother. 2015, 70, 997–1007. [Google Scholar] [CrossRef]
- Pires Dos Santos, T.P.; Damborg, P.; Moodley, A.; Guardabassi, L. Systematic review on global epidemiology of methicillin-resistant Staphylococcus pseudintermedius: Inference of population structure from multilocus sequence typing data. Front. Microbiol. 2016, 7, 1599. [Google Scholar] [CrossRef] [PubMed]
- Trott, D. β-lactam resistance in gram-negative pathogens isolated from animals. Curr. Pharm. Des. 2013, 19, 239–249. [Google Scholar] [CrossRef] [PubMed]
- Abraham, S.; Trott, D.J.; Jordan, D.; Gordon, D.M.; Groves, M.D.; Fairbrother, J.M.; Smith, M.G.; Zhang, R.; Chapman, T.A. Phylogenetic and molecular insights into the evolution of multidrug-resistant porcine enterotoxigenic Escherichia coli in Australia. Int. J. Antimicrob. Agents 2014, 44, 105–111. [Google Scholar] [CrossRef] [PubMed]
- de la Fuente-Nunez, C.; Torres, M.D.; Mojica, F.J.; Lu, T.K. Next-generation precision antimicrobials: Towards personalized treatment of infectious diseases. Curr. Opin. Microbiol. 2017, 37, 95–102. [Google Scholar] [CrossRef]
- Talbot, G.H.; Jezek, A.; Murray, B.E.; Jones, R.N.; Ebright, R.H.; Nau, G.J.; Rodvold, K.A.; Newland, J.G.; Boucher, H.W.; Infectious Diseases Society of America. The Infectious Diseases Society of America’s 10 × ’20 initiative (10 new systemic antibacterial agents us food and drug administration approved by 2020): Is 20 × ’20 a possibility? Clin. Infect. Dis. 2019, 69, 1–11. [Google Scholar] [CrossRef] [PubMed]
- Theuretzbacher, U.; Outterson, K.; Engel, A.; Karlén, A. The global preclinical antibacterial pipeline. Nat. Rev. Genet. 2020, 18, 275–285. [Google Scholar] [CrossRef] [PubMed]
- Bergen, P.J.; Bulman, Z.P.; Saju, S.; Bulitta, J.B.; Landersdorfer, C.; Forrest, A.; Cornelia, J.L.; Nation, R.L.; Tsuji, B.T. Polymyxin combinations: Pharmacokinetics and pharmacodynamics for rationale use. Pharmacother. J. Hum. Pharmacol. Drug Ther. 2015, 35, 34–42. [Google Scholar] [CrossRef]
- Bush, K. New antimicrobial agents for Gram-negative pathogens in pipelines. Int. J. Antimicrob. Agents 2015, 45 (Suppl. 2), S10. [Google Scholar]
- Paytubi, S.; De La Cruz, M.; Balsalobre, C.; Tormo, J.R.; Martín, J.; González, I.; Gonzalez-Menendez, V.; Genilloud, O.; Reyes, F.; Vicente, F.; et al. A high-throughput screening platform of microbial natural products for the discovery of molecules with antibiofilm properties against Salmonella. Front. Microbiol. 2017, 8, 326. [Google Scholar] [CrossRef]
- Bui, T.; Preuss, C.V. Cephalosporins; StatPearls Publishing: Treasure Island, FL, USA, 2020. [Google Scholar]
- José, R.J. Next generation macrolides for community-acquired pneumonia: Will solithromycin rise to the occasion? Ann. Res. Hosp. 2017, 1, 11. [Google Scholar] [CrossRef]
- National Research Council (US) Committee on New Directions in the Study of Antimicrobial Therapeutics. The National Academies Collection: Reports funded by National Institutes of Health. In Treating Infectious Diseases in a Microbial World: Report of Two Workshops on Novel Antimicrobial Therapeutics; National Academies Press: Washington, DC, USA, 2006. [Google Scholar] [CrossRef]
- Fair, R.J.; Tor, Y. Antibiotics and bacterial resistance in the 21st century. Perspect. Med. Chem. 2014, 6, 25–64. [Google Scholar] [CrossRef] [PubMed]
- Morshed, M.T.; Vuong, D.; Crombie, A.; Lacey, A.E.; Karuso, P.; Lacey, E.; Piggott, A.M. Expanding antibiotic chemical space around the nidulin pharmacophore. Org. Biomol. Chem. 2018, 16, 3038–3051. [Google Scholar] [CrossRef]
- Morshed, M.T.; Nguyen, H.T.; Vuong, D.; Crombie, A.; Lacey, E.; Ogunniyi, A.D.; Page, S.W.; Trott, D.J.; Piggott, A.M. Semisynthesis and biological evaluation of a focused library of unguinol derivatives as next-generation antibiotics. Org. Biomol. Chem. 2021, 19, 1022–1036. [Google Scholar] [CrossRef] [PubMed]
- Saputra, S.; Jordan, D.; Worthing, K.; Norris, J.M.; Wong, H.S.; Abraham, R.; Trott, D.J.; Abraham, S. Antimicrobial resistance in coagulase-positive staphylococci isolated from companion animals in Australia: A one year study. PLoS ONE 2017, 12, e0176379. [Google Scholar] [CrossRef]
- Ogunniyi, A.D.; Khazandi, M.; Laven-Law, G.; Tótoli, E.G.; Salgado, H.R.; Pi, H.; Coombs, G.W.; Shinabarger, D.L.; Turnidge, J.D.; Paton, J.C.; et al. Evaluation of robenidine analog NCL195 as a novel broad-spectrum antibacterial agent. PLoS ONE 2017, 12, e0183457. [Google Scholar] [CrossRef]
- CLSI. Performance Standards for Antimicrobial Disk and Dilution Susceptibility Tests For Bacteria Isolated from Animals, 4th ed.; CLSI Supplement VET08; CLSI: Wayne, PA, USA, 2018. [Google Scholar]
- Pi, H.; Nguyen, H.T.; Venter, H.; Boileau, A.R.; Woolford, L.; Garg, S.; Page, S.W.; Russell, C.C.; Baker, J.R.; McCluskey, A.; et al. In vitro activity of robenidine analog NCL195 in combination with outer membrane permeabilizers against Gram-negative bacterial pathogens and impact on systemic Gram-positive bacterial infection in mice. Front. Microbiol. 2020, 11, 1556. [Google Scholar] [CrossRef] [PubMed]
- CLSI. Methods for Determining Bactericidal Activity of Antimicrobial Agents; Approved Guideline; Clinical and Laboratory Standards Institute: Wayne, PA, USA, 1999. [Google Scholar]
- Elemam, A.; Rahimian, J.; Doymaz, M. In vitro evaluation of antibiotic synergy for polymyxin B-resistant carbapenemase-producing Klebsiella pneumoniae. J. Clin. Microbiol. 2010, 48, 3558–3562. [Google Scholar] [CrossRef]
- Hwang, I.-S.; Hwang, J.H.; Choi, H.; Kim, K.-J.; Lee, D.G. Synergistic effects between silver nanoparticles and antibiotics and the mechanisms involved. J. Med. Microbiol. 2012, 61, 1719–1726. [Google Scholar] [CrossRef]
- Khazandi, M.; Pi, H.; Trott, D.J.; Chan, W.Y.; Ogunniyi, A.D.; Sim, J.X.F.; Venter, H.; Garg, S.; Page, S.W.; Hill, P.B.; et al. In vitro antimicrobial activity of robenidine, ethylenediaminetetraacetic acid and polymyxin B nonapeptide against important human and veterinary pathogens. Front. Microbiol. 2019, 10, 837. [Google Scholar] [CrossRef] [PubMed]
- Eid, S.Y.; El-Readi, M.Z.; Wink, M. Synergism of three-drug combinations of sanguinarine and other plant secondary metabolites with digitonin and doxorubicin in multi-drug resistant cancer cells. Phytomedicine 2012, 19, 1288–1297. [Google Scholar] [CrossRef]
- Valgas, C.; Souza, S.M.d.; Smânia, E.F.A.; Smânia, A., Jr. Screening methods to determine antibacterial activity of natural products. Braz. J. Microbiol. 2007, 38, 369–380. [Google Scholar] [CrossRef]
- Hutchings, M.I.; Truman, A.W.; Wilkinson, B. Antibiotics: Past, present and future. Curr. Opin. Microbiol. 2019, 51, 72–80. [Google Scholar] [CrossRef] [PubMed]
- Theuretzbacher, U. Global antimicrobial resistance in Gram-negative pathogens and clinical need. Curr. Opin. Microbiol. 2017, 39, 106–112. [Google Scholar] [CrossRef] [PubMed]
- Wencewicz, T.A. New antibiotics from Nature’s chemical inventory. Bioorg. Med. Chem. 2016, 24, 6227–6252. [Google Scholar] [CrossRef]
- Arzanlou, M.; Chai, W.C.; Venter, H. Intrinsic, adaptive and acquired antimicrobial resistance in Gram-negative bacteria. Essays Biochem. 2017, 61, 49–59. [Google Scholar] [CrossRef] [PubMed]
- Bergen, P.J.; Smith, N.M.; Bedard, T.B.; Bulman, Z.P.; Cha, R.; Tsuji, B.T. Rational combinations of polymyxins with other antibiotics. Adv. Exp. Med. Biol. 2019, 1145, 251–288. [Google Scholar] [CrossRef] [PubMed]
- Zgurskaya, H.I.; López, C.A.; Gnanakaran, S. Permeability barrier of gram-negative cell envelopes and approaches to bypass it. ACS Infect. Dis. 2015, 1, 512–522. [Google Scholar] [CrossRef] [PubMed]

| Compounds | 1 MIC Range (μg/mL) | 2 MBC Range (μg/mL) |
|---|---|---|
| Benzguinol A | 0.5–1 | 4–8 |
| Benzguinol B | 0.5–1 | 4–8 |
| Amikacin | 8–16 | 8–16 |
| Bacteria | MIC (μg/mL) | FICI a | DRI b | ||||||
|---|---|---|---|---|---|---|---|---|---|
| MIC Alone | MIC in Combination | ||||||||
| Colistin | Benzguinol A or Benzguinol B | Colistin | Benzguinol A | Benzguinol B | Colistin + Benzguinol A | Colistin + Benzguinol B | Colistin: Benzguinol A | Colistin: Benzguinol B | |
| A. baumannii ATCC 19606 | 1 | >256 | 0.25 | 2 | 1 | 0.25 * | 0.25 * | 4:128 | 4:256 |
| A. baumannii NCIMB 12457 | 1 | >256 | 0.25 | 2 | 2 | 0.25 * | 0.25 * | 4:128 | 4:128 |
| E. coli Xen14 | 0.25 | >256 | 0.06 | 1 | 2 | 0.25 * | 0.25 * | 4:256 | 4:128 |
| E. coli ATCC 35218 | 0.25 | >256 | 0.06 | 1 | 2 | 0.25 * | 0.25 * | 4:256 | 4:128 |
| E. coli ATCC 25922 | 0.25 | >256 | 0.06 | 1 | 2 | 0.25 * | 0.25 * | 4:256 | 4:128 |
| K. pneumoniae ATCC 13883 | 0.5 | >256 | 0.125 | 2 | 2 | 0.25 * | 0.25 * | 4:128 | 4:128 |
| K. pneumoniae ATCC 33495 | 0.5 | >256 | 0.125 | 2 | 2 | 0.25 * | 0.25 * | 4:128 | 4:128 |
| P. aeruginosa Xen41 | 0.5 | >256 | 0.125 | 2 | 2 | 0.25 * | 0.25 * | 4:128 | 4:128 |
| P. aeruginosa PAO1 | 0.5 | >256 | 0.125 | 2 | 2 | 0.25 * | 0.25 * | 4:128 | 4:128 |
| P. aeruginosa ATCC 27853 | 0.5 | >256 | 0.125 | 2 | 2 | 0.25 * | 0.25 * | 4:128 | 4:128 |
| Drug | Inhibitory Zone (mm) | ||||
|---|---|---|---|---|---|
| Safety Trial | Efficacy Trial | ||||
| Vehicle | 20 mg/kg | Vehicle | 20 mg/kg | 6 mg/kg | |
| Benzguinol A | 8 | 23 | 8 | 22 | ND a |
| Benzguinol B | 8 | 23 | 8 | 23 | ND |
| Daptomycin | 8 | ND | 8 | ND | 27 |
Publisher’s Note: MDPI stays neutral with regard to jurisdictional claims in published maps and institutional affiliations. |
© 2021 by the authors. Licensee MDPI, Basel, Switzerland. This article is an open access article distributed under the terms and conditions of the Creative Commons Attribution (CC BY) license (https://creativecommons.org/licenses/by/4.0/).
Share and Cite
Nguyen, H.T.; Morshed, M.T.; Vuong, D.; Crombie, A.; Lacey, E.; Garg, S.; Pi, H.; Woolford, L.; Venter, H.; Page, S.W.; et al. Evaluation of Benzguinols as Next-Generation Antibiotics for the Treatment of Multidrug-Resistant Bacterial Infections. Antibiotics 2021, 10, 727. https://doi.org/10.3390/antibiotics10060727
Nguyen HT, Morshed MT, Vuong D, Crombie A, Lacey E, Garg S, Pi H, Woolford L, Venter H, Page SW, et al. Evaluation of Benzguinols as Next-Generation Antibiotics for the Treatment of Multidrug-Resistant Bacterial Infections. Antibiotics. 2021; 10(6):727. https://doi.org/10.3390/antibiotics10060727
Chicago/Turabian StyleNguyen, Hang Thi, Mahmud T. Morshed, Daniel Vuong, Andrew Crombie, Ernest Lacey, Sanjay Garg, Hongfei Pi, Lucy Woolford, Henrietta Venter, Stephen W. Page, and et al. 2021. "Evaluation of Benzguinols as Next-Generation Antibiotics for the Treatment of Multidrug-Resistant Bacterial Infections" Antibiotics 10, no. 6: 727. https://doi.org/10.3390/antibiotics10060727
APA StyleNguyen, H. T., Morshed, M. T., Vuong, D., Crombie, A., Lacey, E., Garg, S., Pi, H., Woolford, L., Venter, H., Page, S. W., Piggott, A. M., Trott, D. J., & Ogunniyi, A. D. (2021). Evaluation of Benzguinols as Next-Generation Antibiotics for the Treatment of Multidrug-Resistant Bacterial Infections. Antibiotics, 10(6), 727. https://doi.org/10.3390/antibiotics10060727

